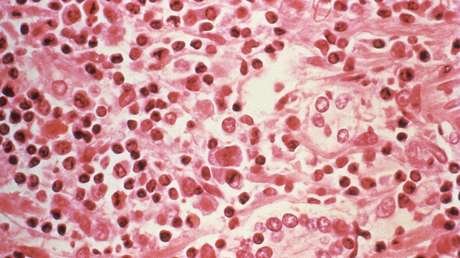
EE.UU.: Detectan un primer caso humano de hantavirus en el estado de Míchigan

El Departamento de Salud y Servicios Humanos del estado de Míchigan (MDHHS), en EE.UU., detectó un primer caso humano de hantavirus en una mujer adulta del condado de Washtenaw, según un comunicado publicado este lunes en su página web.
El texto indica que la mujer tuvo que ser hospitalizada por una enfermedad pulmonar grave causada por dicho virus, del cual se infectó probablemente al limpiar una vivienda desocupada que tenía signos de infestación activa de roedores.
Vías de contagio
La primera vez que se detectó que podía producirse en seres humanos un síndrome pulmonar por hantavirus (HPS, por sus siglas en inglés) fue en 1993, en el suroeste de EE.UU. Desde entonces, el HPS ha infectado a personas en otros puntos del país norteamericano y las Américas.
Las autoridades sanitarias detallan que las infecciones por hantavirus están asociadas con actividades domésticas, ocupacionales o recreativas, que ponen a los humanos en contacto con roedores infectados, y precisan que la mayoría de los casos se han identificado en adultos y suelen ocurrir entre primavera y verano.
"El HPS, causado por algunas cepas de hantavirus, es una enfermedad respiratoria rara pero grave, y a veces fatal, que puede desatarse entre una y cinco semanas después que una persona ha estado expuesta a orina fresca, excrementos o saliva de roedores infectados", explicó Joneigh Khaldun, director médico ejecutivo y director adjunto de salud en el MDHHS.
¿Cuáles son los síntomas?
Los seres humanos se infectan cuando excrementos secos de roedores se voltizan y los inhalan, entran en heridas en la piel o en las membranas mucosas, o cuando ingieren alimentos o agua contaminada. Las mordeduras de roedores también pueden transmitir la enfermedad.
El mayor riesgo de exposición ocurre al estar en edificaciones cerradas que estén infestadas de roedores, en particular al limpiarlas, por lo que se recomienda ventilar previamente el lugar por al menos 30 minutos, portar guantes de látex y usar una solución desinfectante o de cloro.
Los síntomas del HPS, que tiene una tasa de mortalidad del 40 %, incluyen fiebre, escalofríos, dolores corporales, dolor de cabeza y signos gastrointestinales como náuseas, vómitos, diarrea y dolor abdominal. Asimismo, puede provocar tos y dificultad para respirar.
¿Te ha parecido interesante? ¡Déjanos tu opinión en los comentarios!